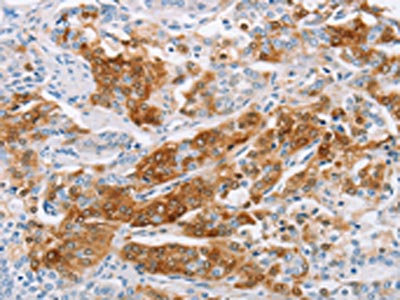

C3AR1 Antibody
-
中文名稱:C3AR1兔多克隆抗體
-
貨號:CSB-PA210441
-
規(guī)格:¥1100
-
圖片:
-
The image on the left is immunohistochemistry of paraffin-embedded Human prostate cancer tissue using CSB-PA210441(C3AR1 Antibody) at dilution 1/25, on the right is treated with fusion protein. (Original magnification: ×200)
-
The image on the left is immunohistochemistry of paraffin-embedded Human cervical cancer tissue using CSB-PA210441(C3AR1 Antibody) at dilution 1/25, on the right is treated with fusion protein. (Original magnification: ×200)
-
-
其他:
產(chǎn)品詳情
-
Uniprot No.:
-
基因名:
-
別名:C3AR1; AZ3B; C3R1; HNFAG09; C3a anaphylatoxin chemotactic receptor; C3AR; C3a-R
-
宿主:Rabbit
-
反應(yīng)種屬:Human
-
免疫原:Fusion protein of Human C3AR1
-
免疫原種屬:Homo sapiens (Human)
-
標(biāo)記方式:Non-conjugated
-
抗體亞型:IgG
-
純化方式:Antigen affinity purification
-
濃度:It differs from different batches. Please contact us to confirm it.
-
保存緩沖液:-20°C, pH7.4 PBS, 0.05% NaN3, 40% Glycerol
-
產(chǎn)品提供形式:Liquid
-
應(yīng)用范圍:ELISA,IHC
-
推薦稀釋比:
Application Recommended Dilution ELISA 1:1000-1:2000 IHC 1:25-1:100 -
Protocols:
-
儲存條件:Upon receipt, store at -20°C or -80°C. Avoid repeated freeze.
-
貨期:Basically, we can dispatch the products out in 1-3 working days after receiving your orders. Delivery time maybe differs from different purchasing way or location, please kindly consult your local distributors for specific delivery time.
-
用途:For Research Use Only. Not for use in diagnostic or therapeutic procedures.
相關(guān)產(chǎn)品
靶點(diǎn)詳情
-
功能:Receptor for the chemotactic and inflammatory peptide anaphylatoxin C3a. This receptor stimulates chemotaxis, granule enzyme release and superoxide anion production.
-
基因功能參考文獻(xiàn):
- High C3aR1 expression is associated with acute myeloid leukemia-M2. PMID: 25426664
- these findings suggest a critical role for C3a through autocrine/paracrine induction of C3aR in the pathogenesis of cigarette smoke-induced sterile inflammation and provide new therapeutic targets for the treatment of emphysema. PMID: 25465103
- Medulloblastoma cells express C3aR, and siRNA-mediated knockdown of C3aR inhibits proliferation of these cells in vitro. PMID: 25603857
- Observed a positive correlation between the expression of anaphylatoxin-receptors C3aR and C5aR with platelet activation in patients with coronary artery disease. PMID: 25544179
- C3aR and CD46 activation via intrinsic generation of their respective ligands is an integral part of human Th1 (but not Th2) immunity. PMID: 24321396
- functional regulation of C3aR by NHERFs in human mast cells PMID: 23284683
- significantly decreased expression of C3aR mRNA and protein expression in placentas with preeclampsia compared to controls PMID: 22901903
- study demonstrates that although C3a causes phosphorylation of its receptor at multiple sites, Ser459, Thr463, Ser465, Thr466 and Ser470 participate in C3aR desensitization PMID: 23077507
- Complement C3a receptor activation contributes to the pathogenesis of preeclampsia. PMID: 22868393
- a new level of complexity for C3aR regulation PMID: 21799898
- shows that both beta-arrestin-1 and beta-arrestin-2 play a novel and shared role in inhibiting G protein-dependent ERK1/2 phosphorylation. These findings reveal a new level of complexity for C3aR regulation by beta-arrestins in human mast cells PMID: 21589858
- Mutant gonococci lacking the pilin glycan did not bind to the I-domain when it is in a closed, low-affinity conformation and cannot induce an active conformation to complement receptor 3 during pex cell challenge. PMID: 21371235
- Sulfation of tyrosine 174 in the human C3a receptor is essential for binding of C3a anaphylatoxin. PMID: 12871936
- determination of whether the levels of complement factors C3a, C4a, and C5a are elevated at the site of inflammation in chronic obstructive pulmonary disease and in asthma PMID: 15039137
- Complement receptor 3 (CR3) is involved in the binding of Leishmania promastigote surface antigen-2 leucine-rich repeat motifs to macrophages, an interaction which can be blocked by anti-CR3 antibodies. PMID: 15067069
- C3a receptor is highly expressed in primary renal proximal tubular epithelial cells in studies that define a new pathway by which complement activation may directly modulate the renal response to immunologic injury. PMID: 15356170
- C3aR is expressed on plasmacytoid dendritic cells. PMID: 16778800
- endothelial cells and subendothelial smooth muscle cells express both C3aR and C5aR PMID: 17234193
- C3a receptor may be used as a unique biomarker of diagnosis and disease activity in patients with lupus nephritis. PMID: 17472841
- In stenotic valves, expression of C3aR mRNA was upregulated PMID: 17498719
- on the basis of the location of C3aR and C5aR, C5aR may play a role in activation of inflammatory cells, whereas C3aR may mediate mucus secretion and mucosal swelling in allergic nasal mucosa, especially severe persistent allergic nasal mucosa PMID: 18538384
顯示更多
收起更多
-
亞細(xì)胞定位:Cell membrane; Multi-pass membrane protein.
-
蛋白家族:G-protein coupled receptor 1 family
-
組織特異性:Widely expressed in several differentiated hematopoietic cell lines, in the lung, spleen, ovary, placenta, small intestine, throughout the brain, heart, and endothelial cells. Mostly expressed in lymphoid tissues.
-
數(shù)據(jù)庫鏈接:
Most popular with customers
-
-
YWHAB Recombinant Monoclonal Antibody
Applications: ELISA, WB, IHC, IF, FC
Species Reactivity: Human, Mouse, Rat
-
Phospho-YAP1 (S127) Recombinant Monoclonal Antibody
Applications: ELISA, WB, IHC
Species Reactivity: Human
-
-
-
-
-